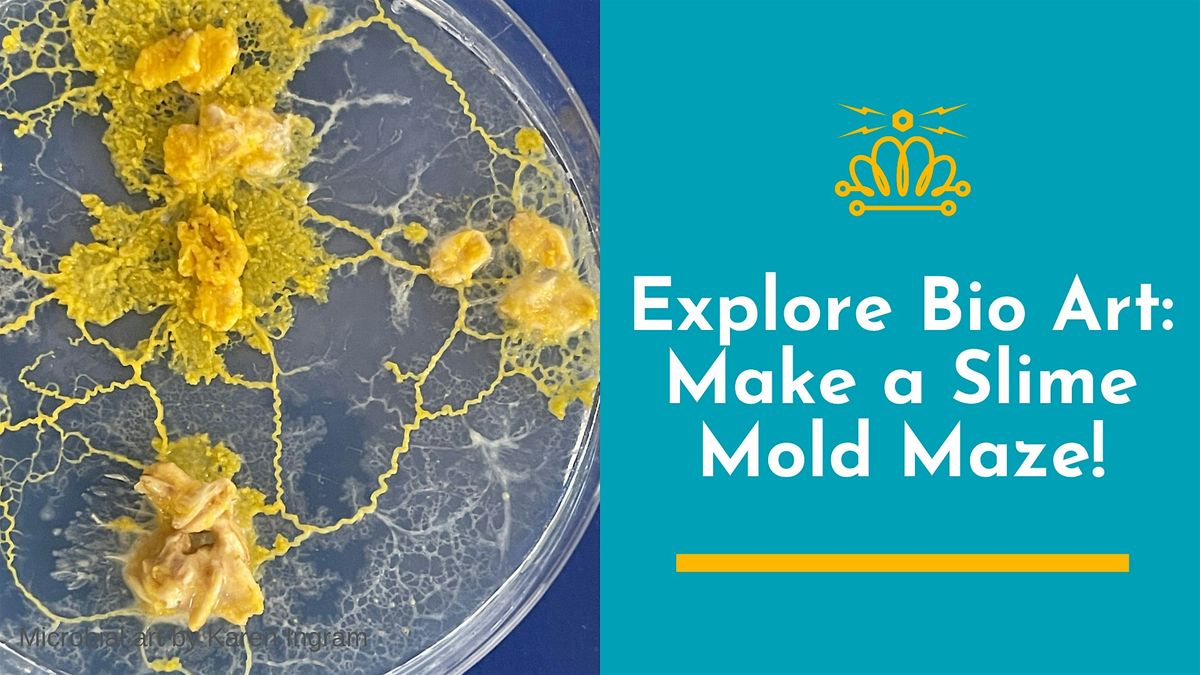

About this Event
*Please note MakerSpace is located at 1003 Louise Ave. Charlotte, NC 28205.
You may recognize Physarum polycephalum, or slime mold; the yellow, ruffled edges, rippled lines, and fanlike shapes. Physarum has appeared in numerous sci-fi stories—"Annihilation," "Vesper," and "The Last of Us" are just a few works of fiction that feature this remarkable single-celled organism.
But did you know this little critter re-drew the Tokyo subway system almost exactly as it was designed by humans? Or that it's being used to plan bike paths, water mains, and power lines?
Get hands-on experience working with this intelligent organism that can solve problems without a brain. Explore how it can inform the way we plan our lives and maybe even reveal insights about our own biochemistry!
In this workshop, you will:
- Explore slime mold in design fiction and design reality
- Create a simple maze for Physarum polycephalum
- Learn how to make slime mold sclerotia
- Take home your slime mold to observe and experiment with on your own
Each participant will receive a Petri dish with slime mold (Physarum polycephalum) to take home with them with instructions on how to care and dispose of the slime mold. The slime mold will grow over the course of a few days, and participants will be encouraged to share photos of their critters as they plot their course to their food source and create their path.
These microorganisms are typically found in woody environments in nature and safe for humans to work with.
This is a class from the new bioart studio at MakerSpace Charlotte. There will be more classes scheduled in the future!
All supplies will be provided.
**Participants should wear closed-toe shoes and pull back long hair. No food or drinks will be permitted while we are working with the microbes.
This class is open to ages 10 and up. Children below the age of 16 must be accompanied by a parent who also has a ticket. For questions about this class, please email [email protected]

About your instructor:
Karen Ingram is an artist, designer, and educator working at the intersection of biotechnology and art for over a decade. Her floral paintings made with genetically modified microbes on Petri dishes have been featured in Nature Biotechnology. She's co-author of "BioBuilder: Synthetic Biology in the Lab" (O'Reilly, 2015), was an Emerging Tech fellow at Stanford's d.school, taught at Genspace (Brooklyn's community biotech lab), and is a member of Biotech Without Borders in Queens, NY. Her work has been exhibited at BioBAT Art Space, London Design Week, and Times Square.
Refund policy:
- Transfers to another class follow the same refund rules as your original date.
- 14+ days before the first class: Full refund.
- 7–13 days before the first class: Refund minus a 50% administrative fee.
- Fewer than 7 days before the first class: No refunds.
- Seat transfer: If you find a replacement who pays for and takes your seat before the first class begins, you are eligible for a full refund.
To cancel or request a transfer, please email [email protected]. For general questions, you’re welcome to visit MakerSpaceCharlotte on Wednesdays at 6:30 PM. For urgent, time-sensitive issues with your reservation, contact Steve at (704) 353-3300.
Class may be canceled due to low enrollment in which case a full refund will be issued.
Cancellation Policy:
MakerSpace reserves the right to cancel any class with insufficient enrollment. If a class is canceled by MakerSpace, fees are 100% refundable.

Event Venue & Nearby Stays
1003 Louise Ave Suite A, 1003 Louise Ave, Charlotte, United States
USD 64.93
